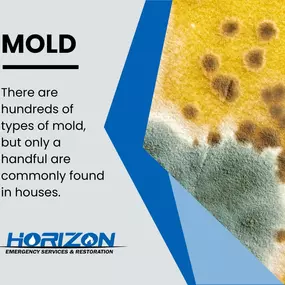
Bild von Horizon Emergency Services & Restoration

Horizon Emergency Services & Restoration in Irving

Openingstijden
- Maandag
- 00:00 - 23:59
- Dinsdag
- 00:00 - 23:59
- Woensdag
- 00:00 - 23:59
- Donderdag
- 00:00 - 23:59
- Vrijdag
- 00:00 - 23:59
- Zaterdag
- 00:00 - 23:59
- Zondag
- 00:00 - 23:59
M-Su 24hr
Opties voor het wijzigen van uw gegevens
Die Seite "Horizon Emergency Services & Restoration" wordt beheerd door een agentschap.Neem contact op met uw agentschapspartner om de inhoud bij te werken.
Horizon Emergency Services & Restoration Aannemers & Architecten
1130 Luke St
75061
Irving
Beschrijving
Horizon Restoration is a team of emergency service experts who understand how stressful water, mold and fire damage can be. We are here for you, 24 hours a day, 7 days a week, 365 days a year. Anytime of the day or night, you can rest assured we will be there for you. Offering the best water damage, mold remediation, fire damage, reconstruction services in Texas, United states.